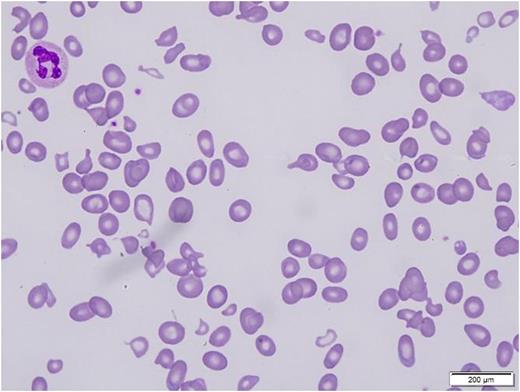
Figure 1.
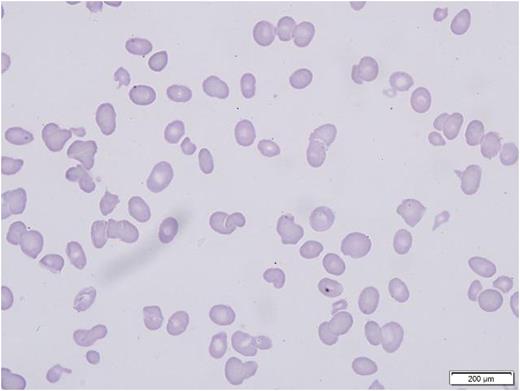
Figure 2.

Abstract
Background:
RBC size variation and microcytes in B12D are often ascribed, but rarely shown, to be due to co-existing Fe deficiency. Schistocytes (aka poikilocytes) were included in early descriptions of pernicious anemia (PA). As it also causes thrombocytopenia, B12D may be confused with thrombotic thrombocytopenic purpura (TTP). Because of the urgency of PP for TTP, it has sometimes been initial therapy for B12D with schistocytes.
Purpose:
Here we describe 3 PA patients, and review reports of 15 other severely anemic B12D cases, with schistocytes. As they are smaller than mature RBC, they may normalize the MCV, while raising the RDW. We wished to determine whether primary lab studies help to distinguish B12D from TTP.
Case Reports:
These patients presented with symptoms of severe anemia:
Ferritins were normal or high, haptoglobins <30, anti-intrinsic factor and parietal cell antibodies present, and complete response to B12 therapy occurred. Significant numbers of schistocytes were present in all, as was a distinctive population of minute, hypochromic schistocytes (MHS).
Review:
We found 15 reports of individual B12D patients with schistocytes, published between 2003 and 2015. All but 2 vegans had PA, 6 being anti-IF Ab+. Median & median ages were 52 & 53, [Hb]'s 5.9 & 6.0, MCV's 120 & 117 (3 normal), platelets 97 & 85, WBC 3200 & 3120, LDH's 4050 & 5860; reticulocyte levels were all low for severe anemia. Iron deficiency anemia was not found; ferritin and/or Fe/TIBC were reported normal in 4. Six legible blood smear microphotographs were included, confirming schistocytosis. Five patients had one or more PP before B12 deficiency was discovered. All 15 responded completely to B12. MHS were also observed on 4 of the 6 legible microphotographs, and noted by authors. For comparison, our survey of 36 reported TTP legible blood smears failed to detect MHC.
Conclusions:
Schistocytes are observed in some severely anemic B12D, may account for as much as 6.7% of RBC, and alter their indices. Schistocytosis and thrombocytopenia suggest TTP, and may lead to unnecessary PP. But such patients' low reticulocyte counts and very high LDH levels are not typical of TTP.
No relevant conflicts of interest to declare.
Author notes
Asterisk with author names denotes non-ASH members.

This feature is available to Subscribers Only
Sign In or Create an Account Close Modal